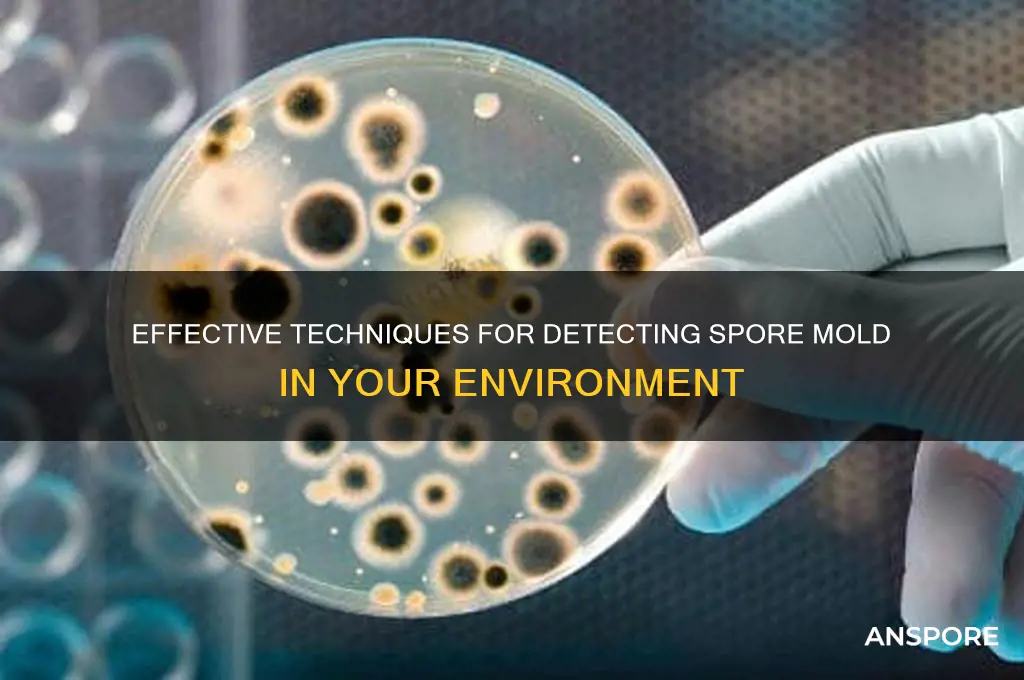
how to detect spore mold

Detecting spore mold is crucial for maintaining a healthy indoor environment, as mold spores can pose serious health risks and damage property. Spore mold often thrives in damp, humid conditions, making areas like bathrooms, basements, and kitchens particularly susceptible. Early detection involves identifying visible signs such as discolored patches on walls, ceilings, or surfaces, which may appear black, green, or white. Additionally, a musty odor is a common indicator of hidden mold growth. To confirm the presence of spore mold, homeowners can use DIY mold test kits or hire professionals for air quality testing, which measures spore concentrations. Regular inspection of moisture-prone areas and addressing leaks or water damage promptly can prevent mold from spreading and ensure a safer living space.
| Characteristics | Values |
|---|---|
| Visual Appearance | Visible mold growth, often fuzzy, powdery, or discolored patches. |
| Color | Varies (black, green, white, gray, brown, or yellow). |
| Texture | Powdery, fuzzy, or slimy depending on the type of mold. |
| Location | Commonly found in damp areas (bathrooms, basements, kitchens, walls). |
| Odor | Musty, earthy, or unpleasant smell. |
| Spores | Microscopic spores may be detected using air sampling or tape lifts. |
| Testing Methods | Air quality tests, surface sampling, mold test kits, professional inspection. |
| Health Symptoms | Allergic reactions, respiratory issues, headaches, or skin irritation. |
| Moisture Indicators | Water stains, peeling paint, or condensation on surfaces. |
| Professional Tools | Moisture meters, borescopes, thermal imaging cameras. |
| Prevention Tips | Control humidity (<60%), fix leaks, ensure proper ventilation. |
Explore related products
What You'll Learn
- Visual Inspection: Look for powdery, fuzzy growths in various colors on surfaces or plants
- Environmental Conditions: Check for high humidity, poor ventilation, and organic matter accumulation
- Microscopic Examination: Use a microscope to identify spore structures and confirm mold presence
- Air Sampling: Collect air samples to detect airborne spores using spore traps or pumps
- Testing Kits: Use mold test kits to identify spore types through swab or tape samples

Visual Inspection: Look for powdery, fuzzy growths in various colors on surfaces or plants
Spore mold often announces its presence through visible signs that are hard to ignore. The most telltale indicator is a powdery or fuzzy growth on surfaces or plants, which can appear in a spectrum of colors ranging from white and gray to green, black, or even pink. These growths thrive in damp, humid environments, making bathrooms, basements, and plant foliage common hotspots. Unlike harmless dust, which can be wiped away easily, mold colonies cling stubbornly to surfaces, spreading as they mature. Recognizing these early visual cues is crucial, as it allows for prompt action before the mold releases spores and exacerbates the problem.
To conduct a thorough visual inspection, start by examining areas prone to moisture accumulation, such as shower tiles, window sills, and potted plant soil. Use a flashlight to illuminate dark corners and crevices where mold might hide. On plants, look for discolored patches or a fuzzy texture on leaves, stems, or soil surfaces. While some molds are obvious, others may appear as subtle discoloration or a thin, almost translucent film. If you notice any suspicious growth, avoid touching it with bare hands, as mold spores can cause allergic reactions or respiratory issues in sensitive individuals.
Comparing mold to other surface contaminants can help ensure accuracy. For instance, efflorescence—a white, crystalline deposit often found on masonry—can resemble mold but dissolves in water, whereas mold does not. Similarly, dirt or pollen can mimic mold’s powdery appearance but lacks its persistent, colony-like structure. If in doubt, consider using a mold test kit to confirm your findings, but visual inspection remains the first and most accessible line of defense.
The takeaway is clear: regular visual inspections are a simple yet effective way to detect spore mold before it becomes a major issue. By staying vigilant and knowing what to look for, you can protect your home, health, and plants from the damaging effects of mold growth. Keep in mind that early detection not only saves time and money but also prevents potential health risks associated with prolonged exposure to mold spores.
Are Moss Spores Identical? Unveiling the Diversity in Moss Reproduction
You may want to see also

Environmental Conditions: Check for high humidity, poor ventilation, and organic matter accumulation
Mold spores thrive in environments that mimic their natural habitats—damp, stagnant, and rich in organic material. High humidity, typically above 60%, creates the moisture mold needs to grow and reproduce. To detect this condition, use a hygrometer, a device that measures relative humidity. Place it in areas prone to moisture, such as basements, bathrooms, or kitchens, and monitor readings regularly. If levels consistently exceed 50%, take immediate steps to reduce humidity, such as using dehumidifiers or fixing leaks. Ignoring this warning sign allows mold to flourish, often unseen, until it becomes a costly problem.
Poor ventilation exacerbates mold growth by trapping moisture and preventing air circulation. In spaces like closets, attics, or rooms with sealed windows, stagnant air creates a breeding ground for spores. To assess ventilation, observe if areas feel stuffy or if condensation forms on surfaces like windows or walls. A simple test: open a window and note if the air feels fresher or if odors dissipate quickly. Improving airflow—through fans, open windows, or vents—can disrupt mold’s ideal environment. Without adequate ventilation, even minor humidity spikes can trigger rapid spore colonization.
Organic matter accumulation provides mold with the nutrients it needs to survive. Common culprits include piles of damp leaves, cardboard boxes in storage, or even dust buildup on surfaces. Inspect areas where organic debris collects, such as under sinks, behind appliances, or in garages. For example, a forgotten stack of wet newspapers in a basement corner can become a mold hotspot within days. Regularly declutter and dispose of organic waste, especially in humid environments. If organic material must remain, ensure it stays dry and well-ventilated to deny mold its food source.
Combining these environmental checks creates a proactive defense against mold. Start by addressing humidity, then tackle ventilation, and finally eliminate organic clutter. For instance, in a bathroom with persistent mold, install an exhaust fan to reduce humidity, open windows during showers, and remove fabric curtains or wooden items that retain moisture. Each step disrupts a critical condition mold relies on, making your space inhospitable to spores. By controlling these factors, you not only detect mold’s presence but also prevent it from taking hold in the first place.
Customize Your Spore Galactic Adventures Plasma Color: A Step-by-Step Guide
You may want to see also

Microscopic Examination: Use a microscope to identify spore structures and confirm mold presence
Under a microscope, mold spores reveal their distinctive shapes, sizes, and colors, offering a definitive way to confirm their presence. Unlike surface-level observations, which can be misleading, microscopic examination provides a detailed view of spore structures, allowing for accurate identification. For instance, *Aspergillus* spores appear as clusters of spherical or oval shapes, while *Penicillium* spores form brush-like structures. This method is particularly useful when dealing with hidden or early-stage mold growth, where visual inspection alone may not suffice.
To perform a microscopic examination, start by collecting a sample from the suspected area using a sterile swab or tape lift. Place the sample on a glass slide and cover it with a thin layer of clear adhesive tape to secure the spores. Alternatively, use a drop of water or mounting medium to suspend the spores for better visibility. Set your microscope to a magnification of 400x to 1000x, as this range typically provides the best balance between detail and field of view. Adjust the lighting and focus until the spore structures become clear, noting their morphology, arrangement, and any unique features.
One of the key advantages of microscopic examination is its ability to differentiate between mold spores and other particles, such as dust or pollen. For example, mold spores often exhibit a textured surface or distinct pigmentation, whereas pollen grains are smoother and more uniform. Additionally, mold spores tend to cluster in specific patterns, which can be a telltale sign of their presence. However, this method requires practice and familiarity with spore morphology, as misidentification can lead to incorrect conclusions. Reference guides or atlases of mold spores can be invaluable tools for accurate analysis.
Despite its precision, microscopic examination is not without limitations. It requires access to a microscope, which may not be readily available for everyone. Moreover, the process can be time-consuming, especially when analyzing multiple samples. For non-experts, interpreting spore structures may also pose a challenge, necessitating consultation with a specialist. Nonetheless, when combined with other detection methods, such as air sampling or moisture meters, microscopic examination becomes a powerful tool in the fight against mold.
In practical terms, this technique is particularly useful for professionals in fields like environmental testing, home inspection, or mycology. For homeowners, investing in a basic microscope and learning the fundamentals of spore identification can provide long-term benefits, especially in mold-prone environments. Regular microscopic examinations of high-risk areas, such as basements or bathrooms, can help detect mold early, preventing costly remediation efforts. Ultimately, while it may seem technical, mastering this method empowers individuals to take proactive steps in maintaining a mold-free space.
Do Ferns Have Spores? Unveiling Their Unique Reproduction Process
You may want to see also
Explore related products

Air Sampling: Collect air samples to detect airborne spores using spore traps or pumps
Airborne spores are invisible threats that can compromise indoor air quality and health, making their detection a critical step in mold remediation. Air sampling, a precise and scientific method, offers a direct way to identify and quantify these microscopic particles. By using spore traps or air pumps, you can collect samples that reveal the presence and concentration of mold spores, providing actionable data for assessment and mitigation.
Steps to Conduct Air Sampling:
- Select the Right Equipment: Spore traps, such as adhesive-coated slides, capture spores as air passes through them, while air pumps draw a measured volume of air onto a collection medium. Choose based on your need for qualitative (spore types) or quantitative (spore counts) data.
- Determine Sampling Locations: Focus on areas prone to moisture, like basements, bathrooms, or near HVAC systems. Include control samples from outdoor air to differentiate between indoor and outdoor spore sources.
- Operate the Device Correctly: For spore traps, place them in the sampling area for 5–15 minutes, ensuring they are at breathing height (3–5 feet). Air pumps require calibration to collect a specific volume (e.g., 75 liters of air) for accurate quantification.
- Analyze the Sample: Send the collected medium to a laboratory for microscopic analysis. Results typically include spore types, concentrations, and comparisons to outdoor levels, helping identify problem areas.
Cautions and Considerations:
- Avoid sampling during or immediately after cleaning activities, as this can skew results by disturbing settled spores.
- Ensure the sampling device is clean and free of contaminants to prevent false positives.
- Interpret results cautiously; elevated spore counts alone do not confirm active mold growth but indicate a potential issue.
Air sampling is a powerful tool for detecting airborne spores, offering both specificity and quantifiability. When paired with visual inspections and moisture assessments, it provides a comprehensive view of mold risks. Whether for residential, commercial, or industrial settings, this method ensures informed decisions and targeted interventions to maintain healthy indoor environments.
Mange Mites and Dog Aggression: Unraveling the Behavioral Connection
You may want to see also

Testing Kits: Use mold test kits to identify spore types through swab or tape samples
Mold test kits offer a straightforward, accessible method for homeowners and professionals alike to identify spore types through swab or tape samples. These kits typically include swabs or adhesive tapes designed to collect mold spores from surfaces, which are then analyzed to determine the type and concentration of mold present. The process is simple: swab or press the tape onto the suspected moldy area, seal the sample, and send it to a lab for testing. Results usually provide detailed information about the mold species, helping users understand potential health risks and necessary remediation steps.
Analyzing the effectiveness of these kits reveals both strengths and limitations. Swab tests are ideal for smooth surfaces like walls or countertops, where mold spores can be easily collected. Tape samples, on the other hand, are better suited for textured or porous materials like drywall or fabric, as the adhesive can capture spores embedded in the surface. However, neither method guarantees 100% accuracy, as the sample collection process can be influenced by user technique and the condition of the tested area. Labs typically use microscopy or DNA analysis to identify spore types, but results may take several days to a week, requiring patience from the user.
For those considering mold test kits, practical tips can enhance accuracy and reliability. First, ensure the area to be tested is dry, as moisture can interfere with sample collection. Avoid touching the swab or tape to prevent contamination. If using a tape sample, press firmly but gently to avoid damaging the surface. Label samples clearly with the location and date to track results effectively. Additionally, follow the kit’s instructions precisely, as deviations can compromise the lab’s ability to analyze the sample. For best results, test multiple areas, especially if mold is suspected in more than one location.
Comparing mold test kits to professional inspections highlights their cost-effectiveness and convenience. While professional mold assessments are thorough and immediate, they can be expensive, ranging from $300 to $900 depending on the property size and complexity. Mold test kits, in contrast, typically cost between $10 and $50, making them an affordable option for initial investigations. However, they are best used as a preliminary tool rather than a definitive solution. If results indicate high spore counts or toxic mold species, consulting a professional for further evaluation and remediation is strongly recommended.
In conclusion, mold test kits provide a practical, user-friendly approach to identifying spore types through swab or tape samples. While they offer valuable insights into mold presence and type, their effectiveness depends on proper usage and realistic expectations. By following specific guidelines and understanding their limitations, users can leverage these kits as a first line of defense against mold-related issues, ensuring a healthier living environment.
Do Spores Require Sperm Fertilization for Reproduction and Growth?
You may want to see also
Frequently asked questions
Spore mold often appears as powdery or fuzzy growth in colors like white, green, black, or brown. It typically forms on surfaces such as walls, ceilings, or organic materials like wood or plants.
You can use a mold test kit to collect samples from suspect areas. These kits often include swabs or tape lifts to gather spores, which are then sent to a lab for analysis. Alternatively, hire a professional mold inspector for accurate testing.
Tools like moisture meters can identify damp areas where mold thrives. Air quality testers can detect airborne spores, and UV lights may highlight mold growth in hidden areas. Professional inspectors also use thermal imaging cameras to find moisture sources.

























